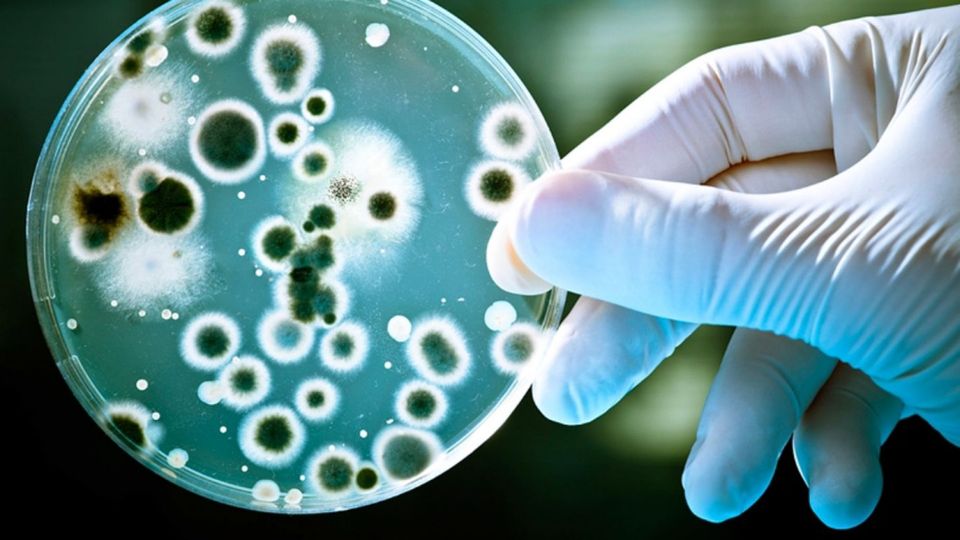
Бруцеллез - хронически протекающая болезнь животных и человека.

Основными источниками возбудителя инфекции для людей при бруцеллезе являются овцы, козы, крупный рогатый скот, верблюды, свиньи, маралы и другие виды животных.
К ведущим факторам передачи относятся продукты и сырье животного происхождения, инфицированные бруцеллами, предметы ухода, корма, подстилка, вода, почва, одежда людей.
Болезнь в хозяйстве может возникать после ввода в стадо животных из других хозяйств, при несоблюдении основных правил карантинирования поголовья, при совместном выпасе здоровых и больных животных, использовании для поения скота инфицированных водоисточников, скотопрогонных трасс.
В свежих эпизоотических очагах бруцеллеза в течение нескольких месяцев может быть инфицировано до 60 % и более восприимчивого поголовья.
В целях недопущения распространения заболевания два раза в год проводятся диагностические исследования на бруцеллез.
Лицам, которые занимаются содержанием и разведением сельскохозяйственных животных, при выявлении положительно реагирующих животных на бруцеллез, необходимо знать следующее.
В соответствии с Порядком проведения ветеринарных мероприятий по бруцеллезу владельцы обязаны изолировать больных животных от остальных животных и в течение не более 15 календарных дней сдать на санитарный убой на мясокомбинаты или убойные пункты. После отправки животного на санитарный убой, в помещении, где находилось больное животное, необходимо произвести механическую очистку (удаление навоза, кормов) для дальнейшей дезинфекции помещения сотрудниками ветеринарной службы.
При сдаче бруцеллезного скота на санитарный убой ветеринарный врач лаборатории непосредственно на объекте убоя проводит ветеринарно-санитарную экспертизу, при которой определяется ветеринарно-санитарная оценка туши мяса.
Согласно правилам ветеринарно-санитарной оценки мяса животных, больных бруцеллезом (кроме туш овец и коз), при отсутствии патологоанатомических изменений в тушах и органах выпускают без ограничения после 12 часового созревания мяса.
При получении такого заключения, владельцы животных могут на основании выданного акта ветеринарно-санитарной экспертизы осуществить дальнейшую реализацию полученной туши мяса от положительно реагирующих животных на бруцеллез по рыночной цене на объектах внутренней торговли (магазины, рынки) или оставить туши мяса на объекте убоя также по рыночной цене на свое усмотрение.
Поэтому, владельцам мяса, получившим акт экспертизы об использовании их без ограничений при бруцеллезе крупного рогатого скота, свиней, верблюдов и лошадей, не выплачивается возмещение стоимости животных, продукции и сырья животного происхождения.
То есть, выплачивается возмещение стоимости при бруцеллезе животных только при наличии патологоанатомических изменений в тушах и органах, которые направляются на обязательное обезвреживание (обеззараживание) и переработку. Возмещение производится из расчета за один килограмм продукции животного происхождения за счет местного бюджета в размере 30 % от среднемесячной рыночной стоимости, а остальная часть среднемесячной рыночной стоимости (70 %) выплачивается организацией по переработке продукции и сырья животного происхождения.
Перечень необходимых документов при возмещении стоимости при обязательном обезвреживании (обеззараживании) и переработке без изъятия животных, положительно реагирующих на бруцеллез.
1.Акт экспертизы (протокол испытаний);
2.Предписание об обезвреживании (обеззараживании);
3.Акт о сдаче на переработку животных, продукции;
4.Акт об установлении среднемесячной рыночной стоимости;
5.Ветеринарный паспорт;
6.Выписка из базы данных по идентификации сельскохозяйственных животных.
Для предупреждения заболевания бруцеллезом необходимо владельцам всех форм собственности предоставлять животных специалистам ветеринарной службы для проведения обязательных противоэпизоотических мероприятий, производить регистрацию животных в ветеринарных станциях районов и города Петропавловска.
Уважаемые жители Северо-Казахстанской области! Бруцеллез является опасным заболеванием, общим для человека и животного. Соблюдайте меры безопасности и профилактики бруцеллёза.
Ветстанция Тимирязевского района